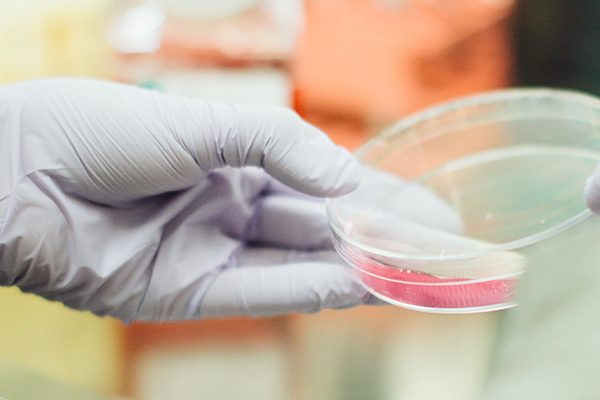
Infertility-test-results-Jeevan

How Common Is Infertility? Understanding the Facts
Infertility is a condition affecting millions of people worldwide, often in silence and solitude. For many couples, the path to parenthood is not always straightforward, and understanding how common infertility…